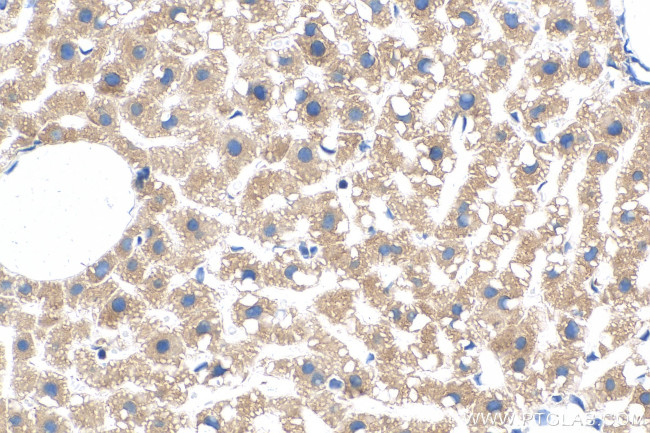
MTHFD1L Antibody in Immunohistochemistry (Paraffin) (IHC (P))

Search
Proteintech
MTHFD1L Monoclonal Antibody (1G1F2)
{{$productOrderCtrl.translations['antibody.pdp.commerceCard.promotion.promotions']}}
{{$productOrderCtrl.translations['antibody.pdp.commerceCard.promotion.viewpromo']}}
{{$productOrderCtrl.translations['antibody.pdp.commerceCard.promotion.promocode']}}: {{promo.promoCode}} {{promo.promoTitle}} {{promo.promoDescription}}. {{$productOrderCtrl.translations['antibody.pdp.commerceCard.promotion.learnmore']}}
产品信息
68321-1-IG
种属反应
宿主/亚型
分类
类型
克隆号
抗原
偶联物
形式
纯化类型
保存液
内含物
保存条件
运输条件
产品详细信息
Immunogen sequence: GRMVVASDKS GQPVTADDLG VTGALTVLMK DAIKPNLMQT LEGTPVFVHA GPFANIAHGN SSVLADKIAL KLVGEEGFVV TEAGFGADIG MEKFFNIKCR ASGLVPNVVV LVATVRALKM HGGGPSVTAG VPLKKEYTEE NIQLVADGCC NLQKQIQITQ LFGVPVVVAL NVFKTDTRAE IDLVCELAKR AGAFDAVPCY HWSVGGKGSV DLARAVREAA SKRSRFQFLY DVQVPIVDKI RTIAQAVYGA KDIELSPEAQ AKIDRYTQQG FGNLPICMAK THLSLSHQPD KKGVPRDFIL PISDVRASIG AGFIYPLVGT MSTMPGLPTR PCFYDIDLDT ETEQVKGLF
靶标信息
One-carbon substituted forms of tetrahydrofolate (THF) are involved in the de novo synthesis of purines and thymidylate and support cellular methylation reactions through the regeneration of methionine from homocysteine. MTHFD1L is an enzyme involved in THF synthesis in mitochondria (Christensen et al., 2005 [PubMed 15611115]).
仅用于科研。不用于诊断过程。未经明确授权不得转售。
篇参考文献 (0)
生物信息学
蛋白别名: 10-formyl-THF synthetase; Formyltetrahydrofolate synthetase; formyltetrahydrofolate synthetase domain containing 1; Monofunctional C1-tetrahydrofolate synthase, mitochondrial; unnamed protein product
基因别名: dJ292B18.2; FTHFSDC1; MTC1THFS; MTHFD1L
UniProt ID: (Human) Q6UB35
Entrez Gene ID: (Rabbit) 100343064, (Human) 25902, (Rat) 361472